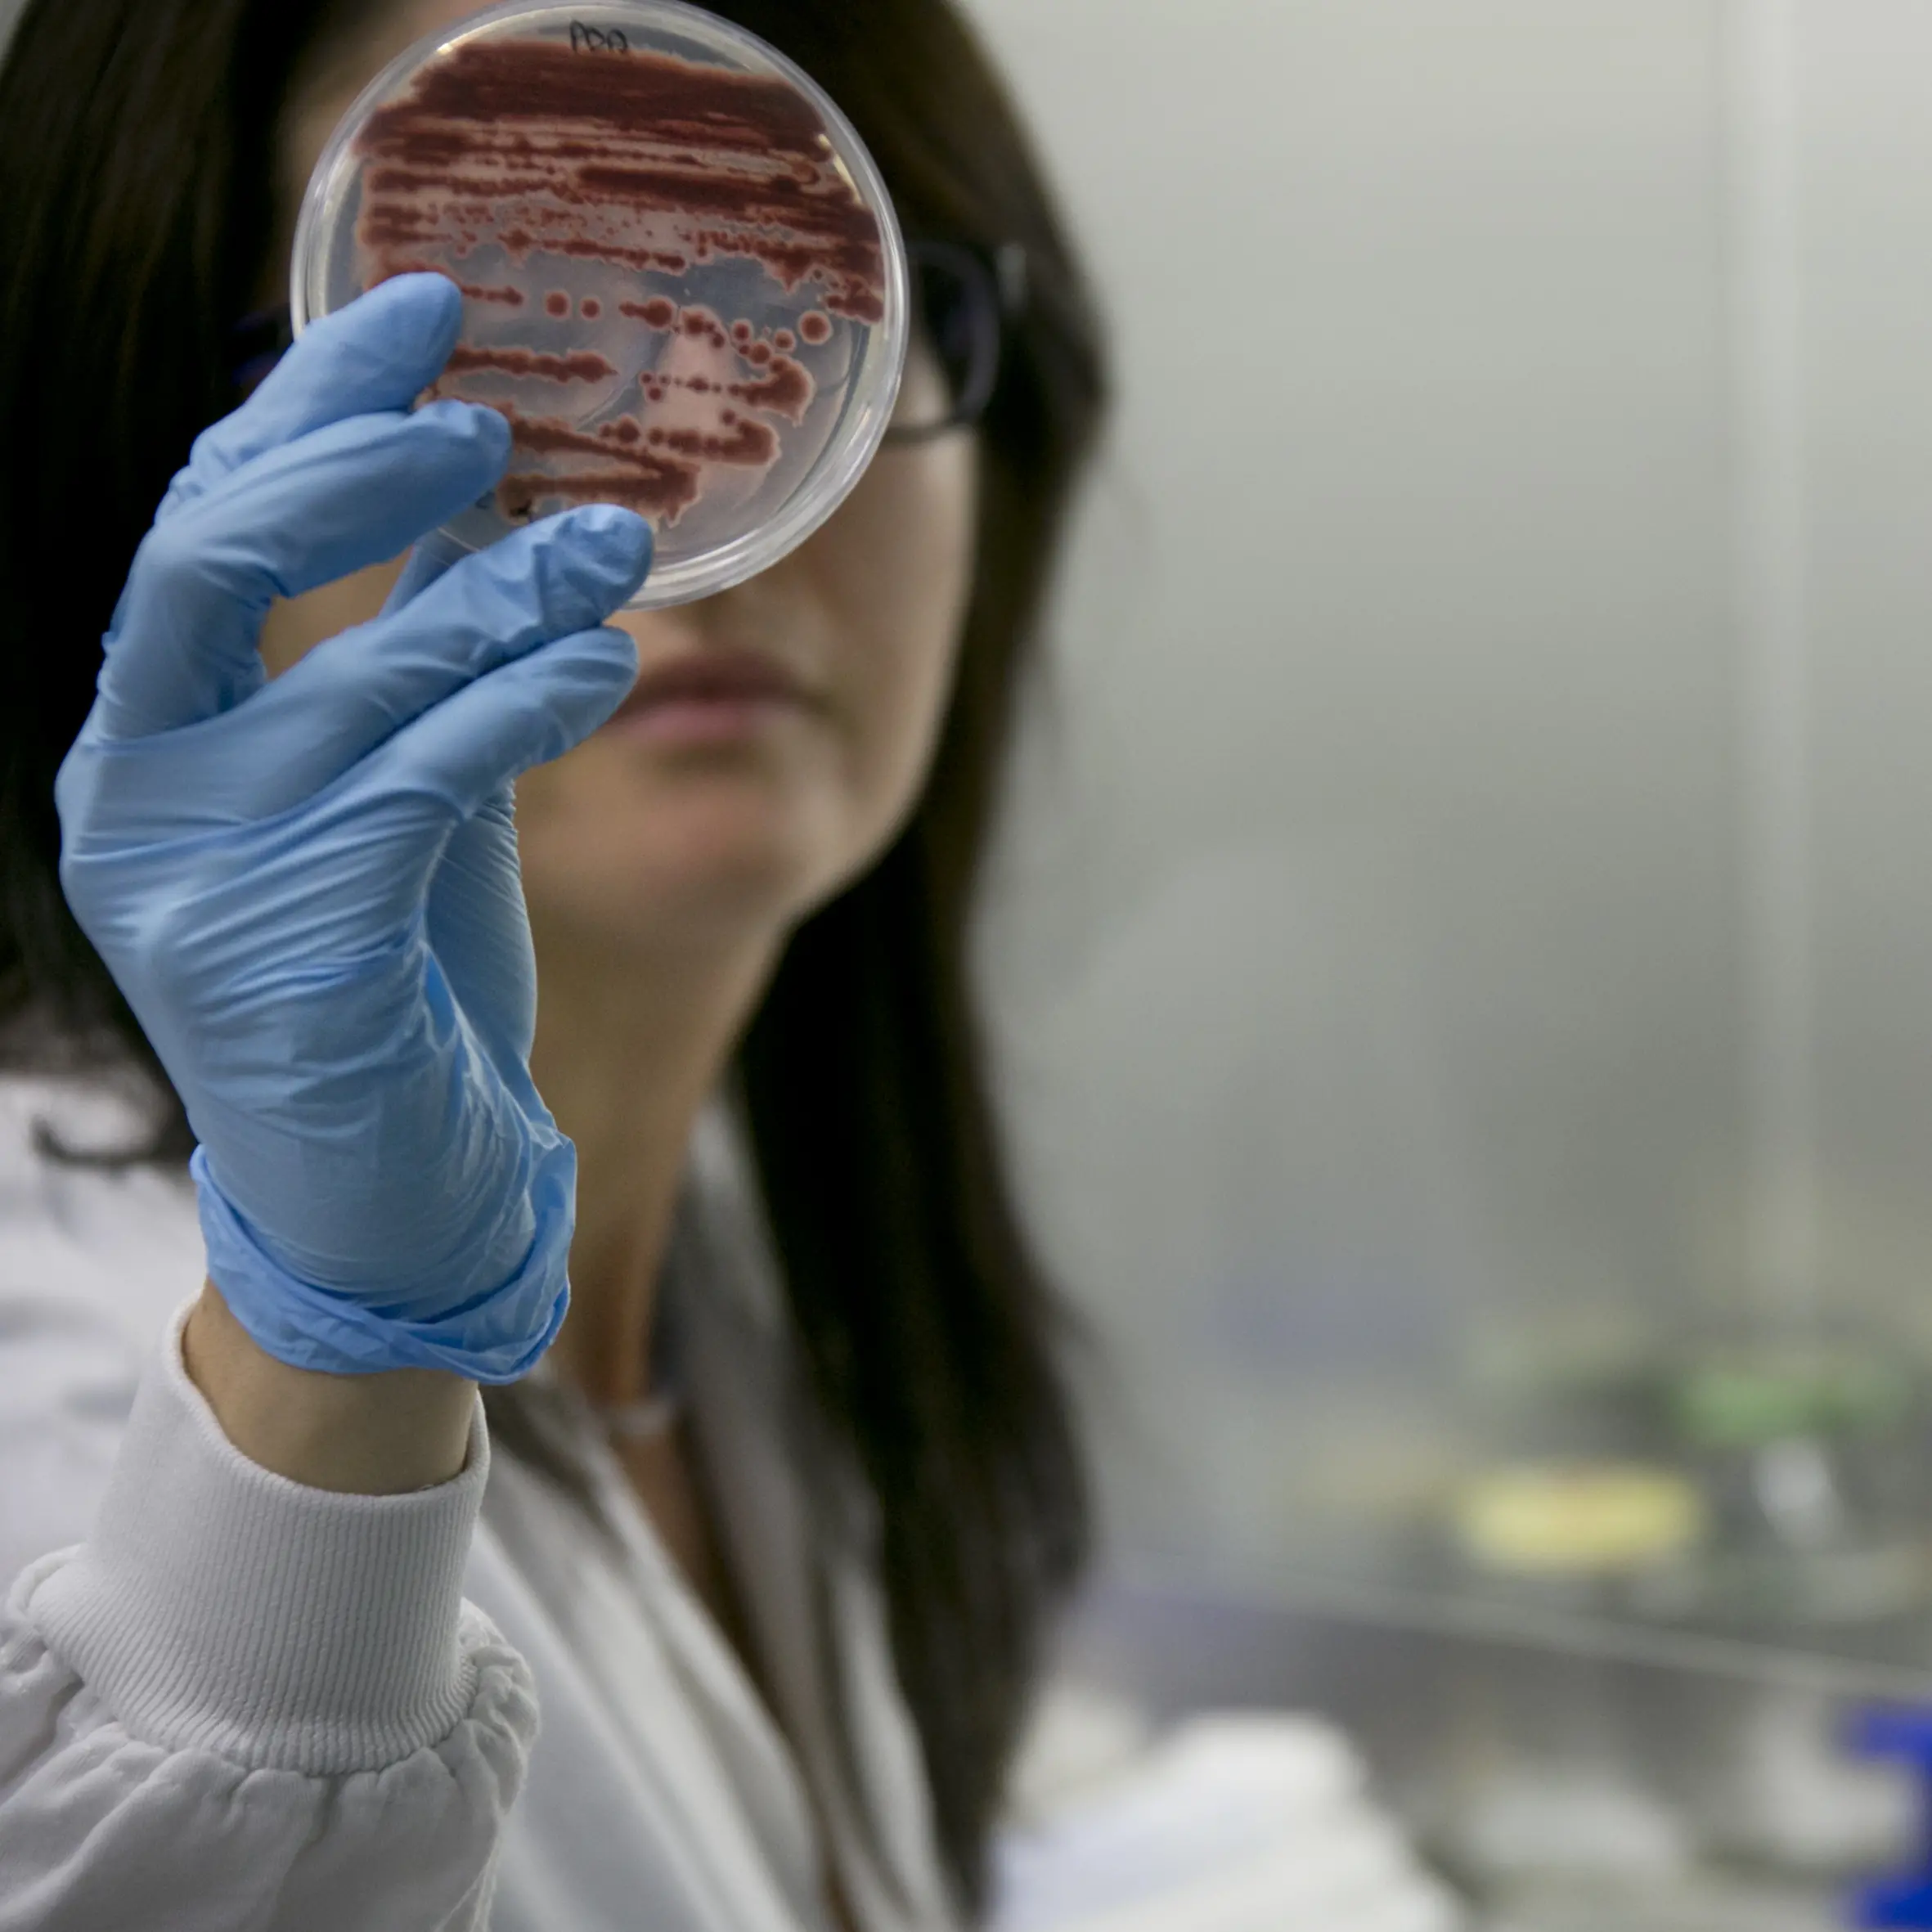
Chimica di base in Europa, vertice d’emergenza a Bruxelles

PHOTO
Il Comune di Roma è diffidato a ritirare entro questa domenica il bando di gara per il servizio di contact center Chiama Roma 060606. A chiederne la revoca immediata sono i sindacati, che denunciano una violazione: pubblicato lo scorso 3 dicembre, il bando trasgredisce l’accordo per un lavoro tutelato negli appalti firmato dal Comune stesso e Cgil, Cisl, Uil appena un mese prima. “Contraddice, inoltre – si legge in una dichiarazione congiunta delle categorie – la nota 6143 del ministero del Lavoro, che indica nel ccnl Telecomunicazioni, sottoscritto da Slc-Cgil, Fistel-Cisl, Uilcom-Uil e Asstel, il contratto di riferimento negli appalti, soprattutto nel settore dei call center.” Elude, infine, la garanzia del principio di territorialità previsto dalla clausola sociale, causando 125 esuberi potenziali.
Il caso è scoppiato dopo che il sindaco Roberto Gualtieri ha sottoscritto un bando di gara che indica, per lo svolgimento del noto servizio di assistenza telefonica ai cittadini della Capitale, il contratto di lavoro delle Cooperative sociali. Tale contratto prevede, rispetto a quello delle telecomunicazioni, retribuzioni più basse e minori tutele. Inoltre “ha scarsa attinenza al codice Ateco dell’attività in questione – concludono i sindacati – ed è nettamente meno rappresentativo e applicato”.